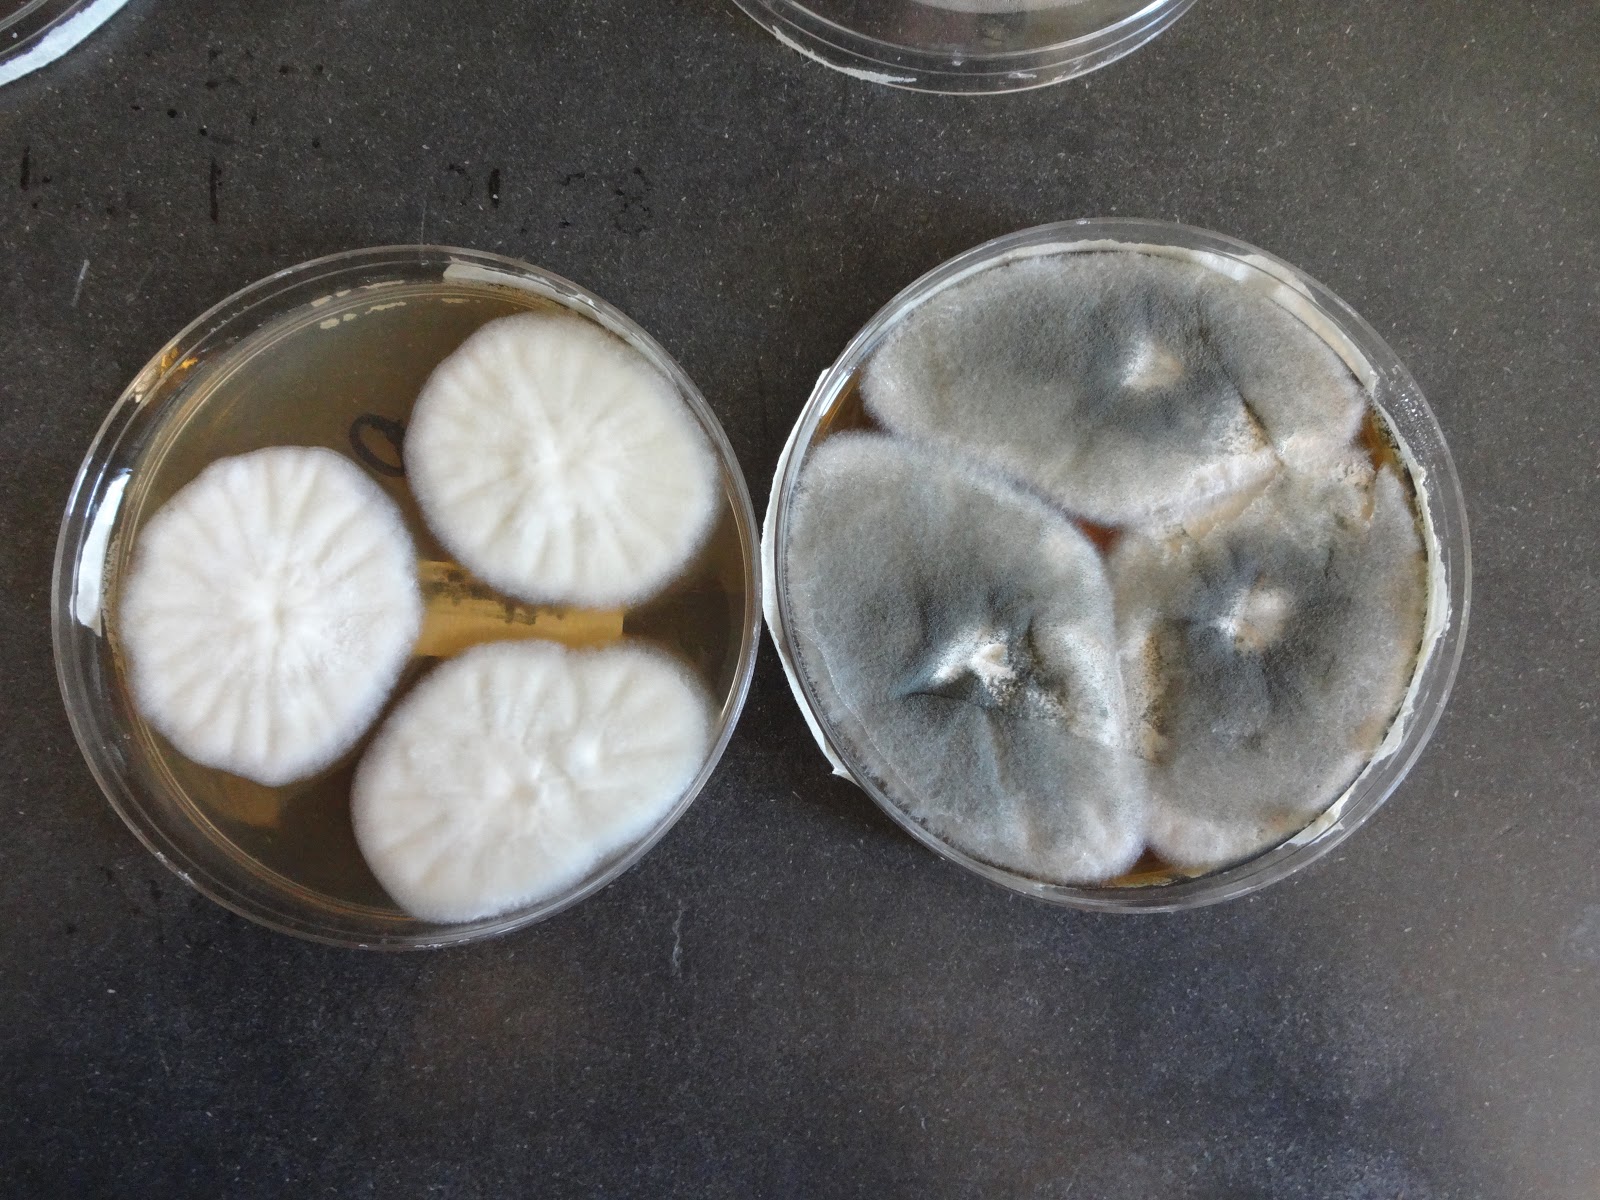

|
| Dr. Larry Wackett |
Dr. Larry Wackett gave a talk on bioremediation of shale Fracking water at our University of Minnesota staff retreat. He uses bacteria encased in a filter media to breakdown a wide variety of chemicals into carbon dioxide and water. He is looking for a partner to scale it up for on site application.
The U of MN news service also provided a feature article on Cleaning up water from Fracking
Summary of Dr. Larry Wackett's Talk